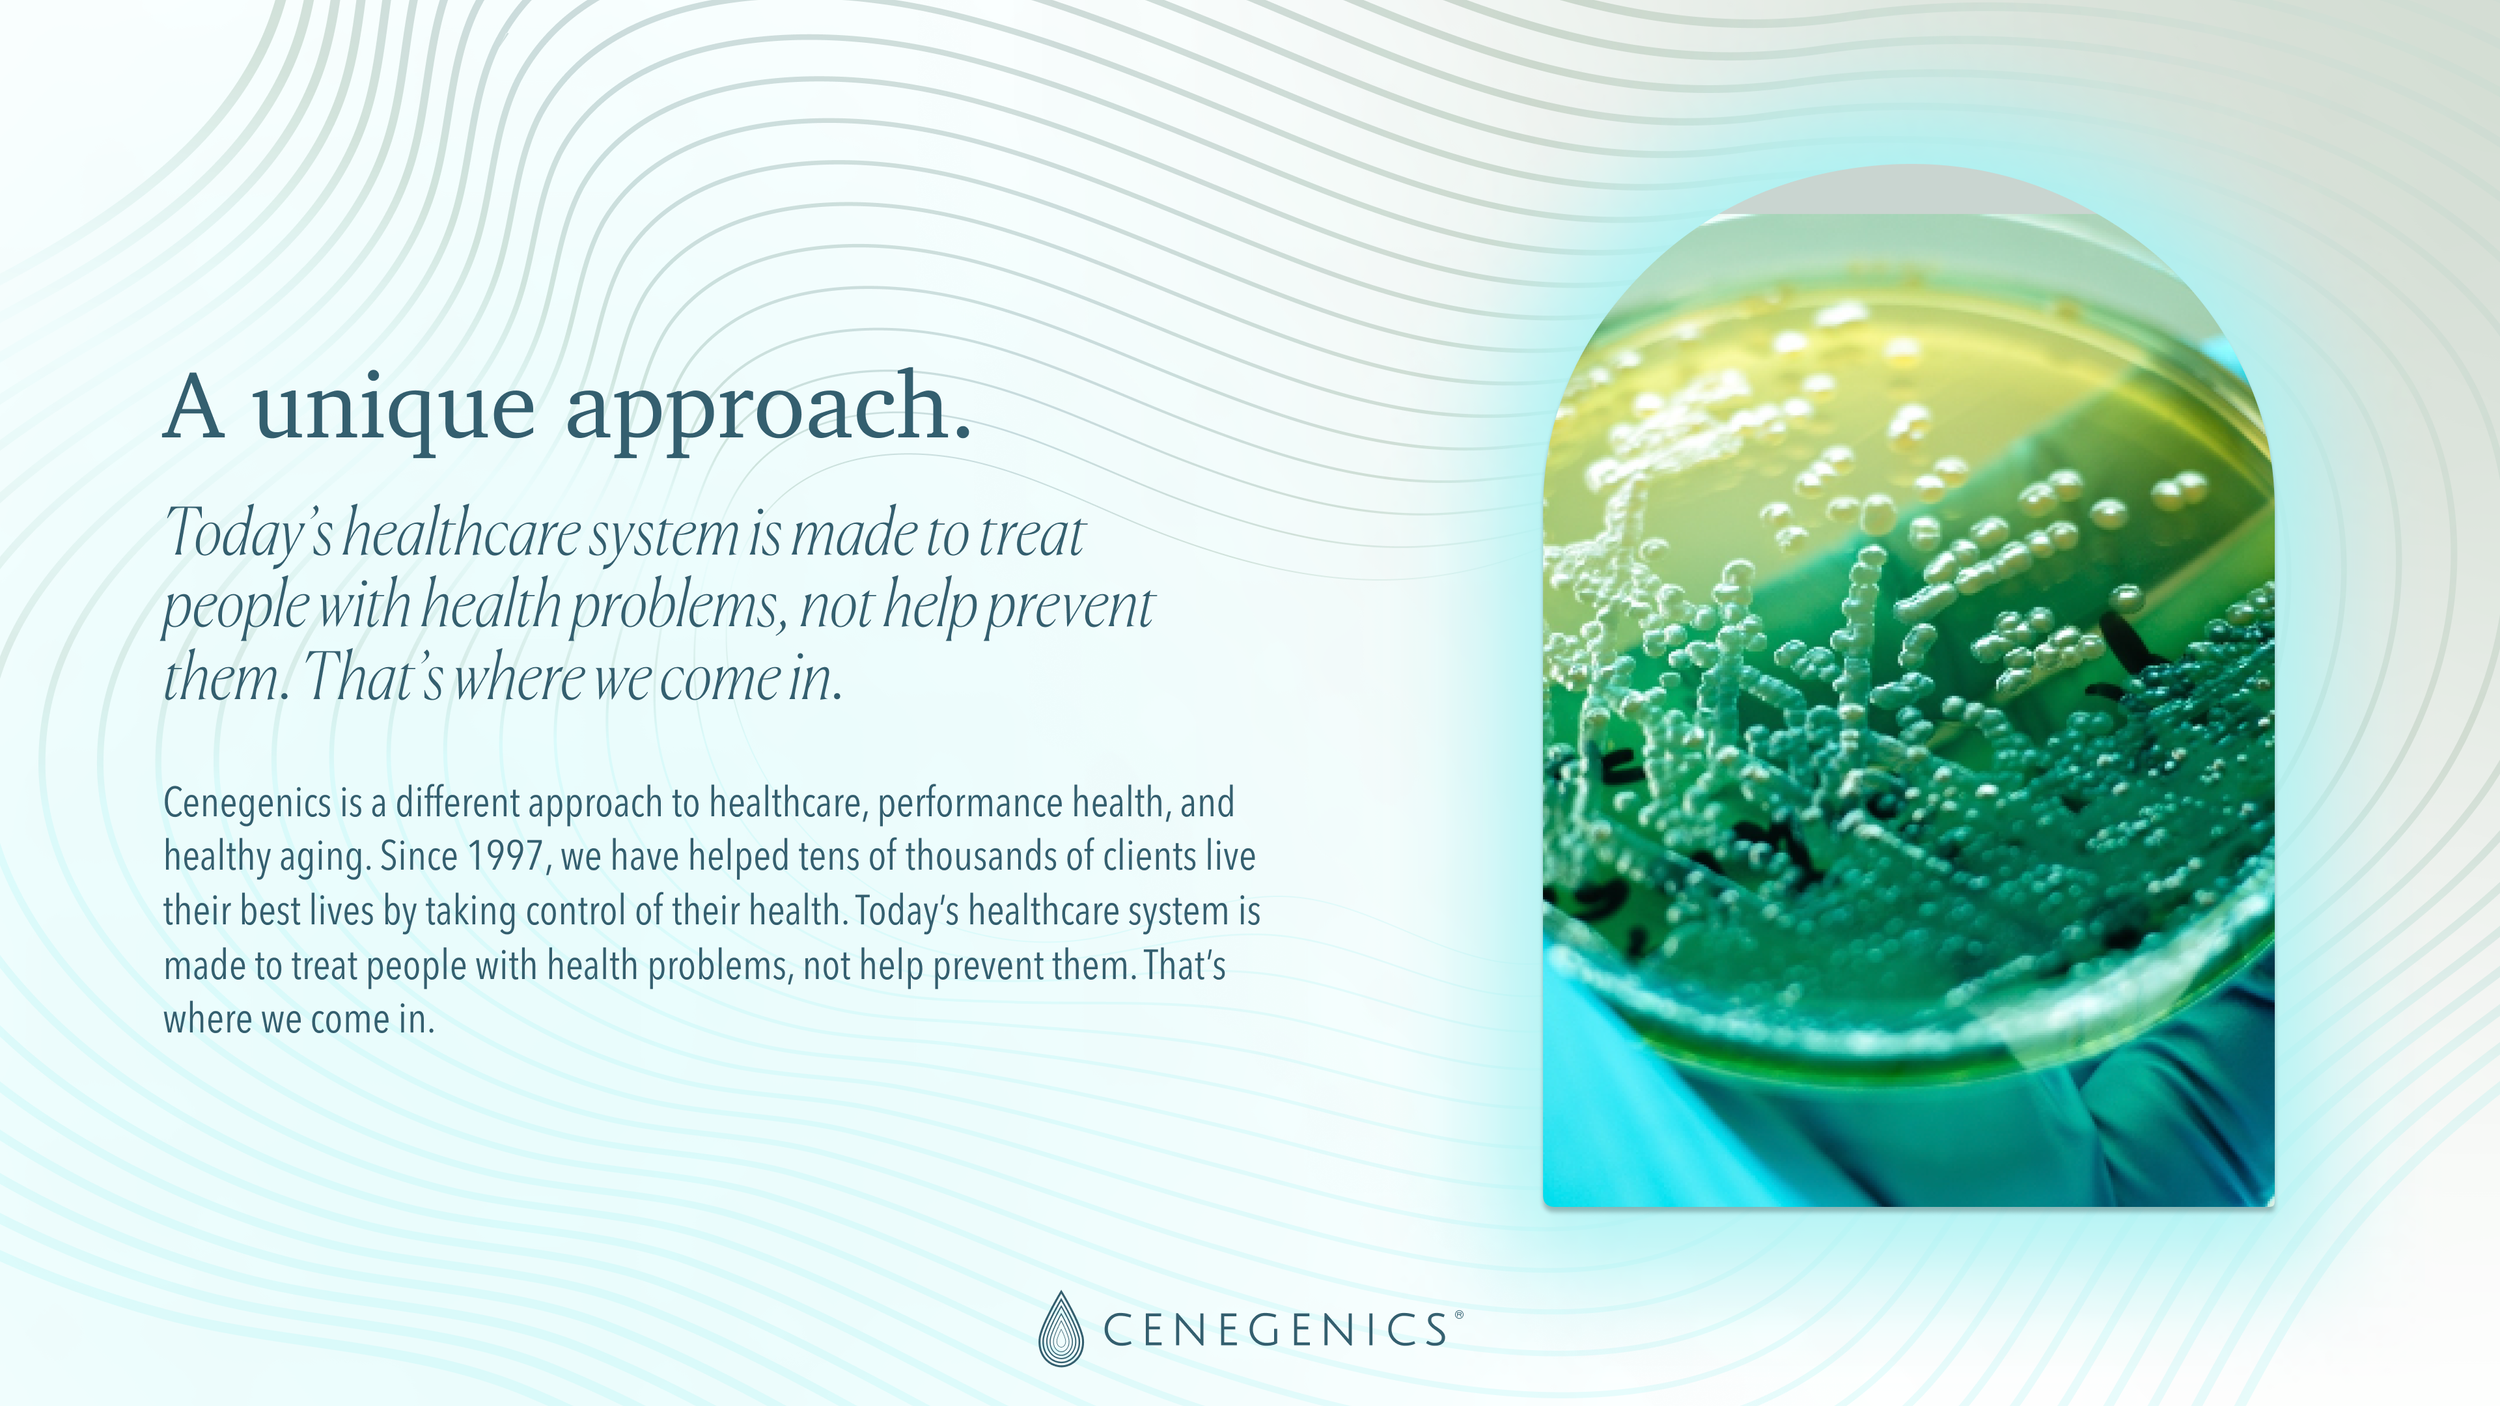
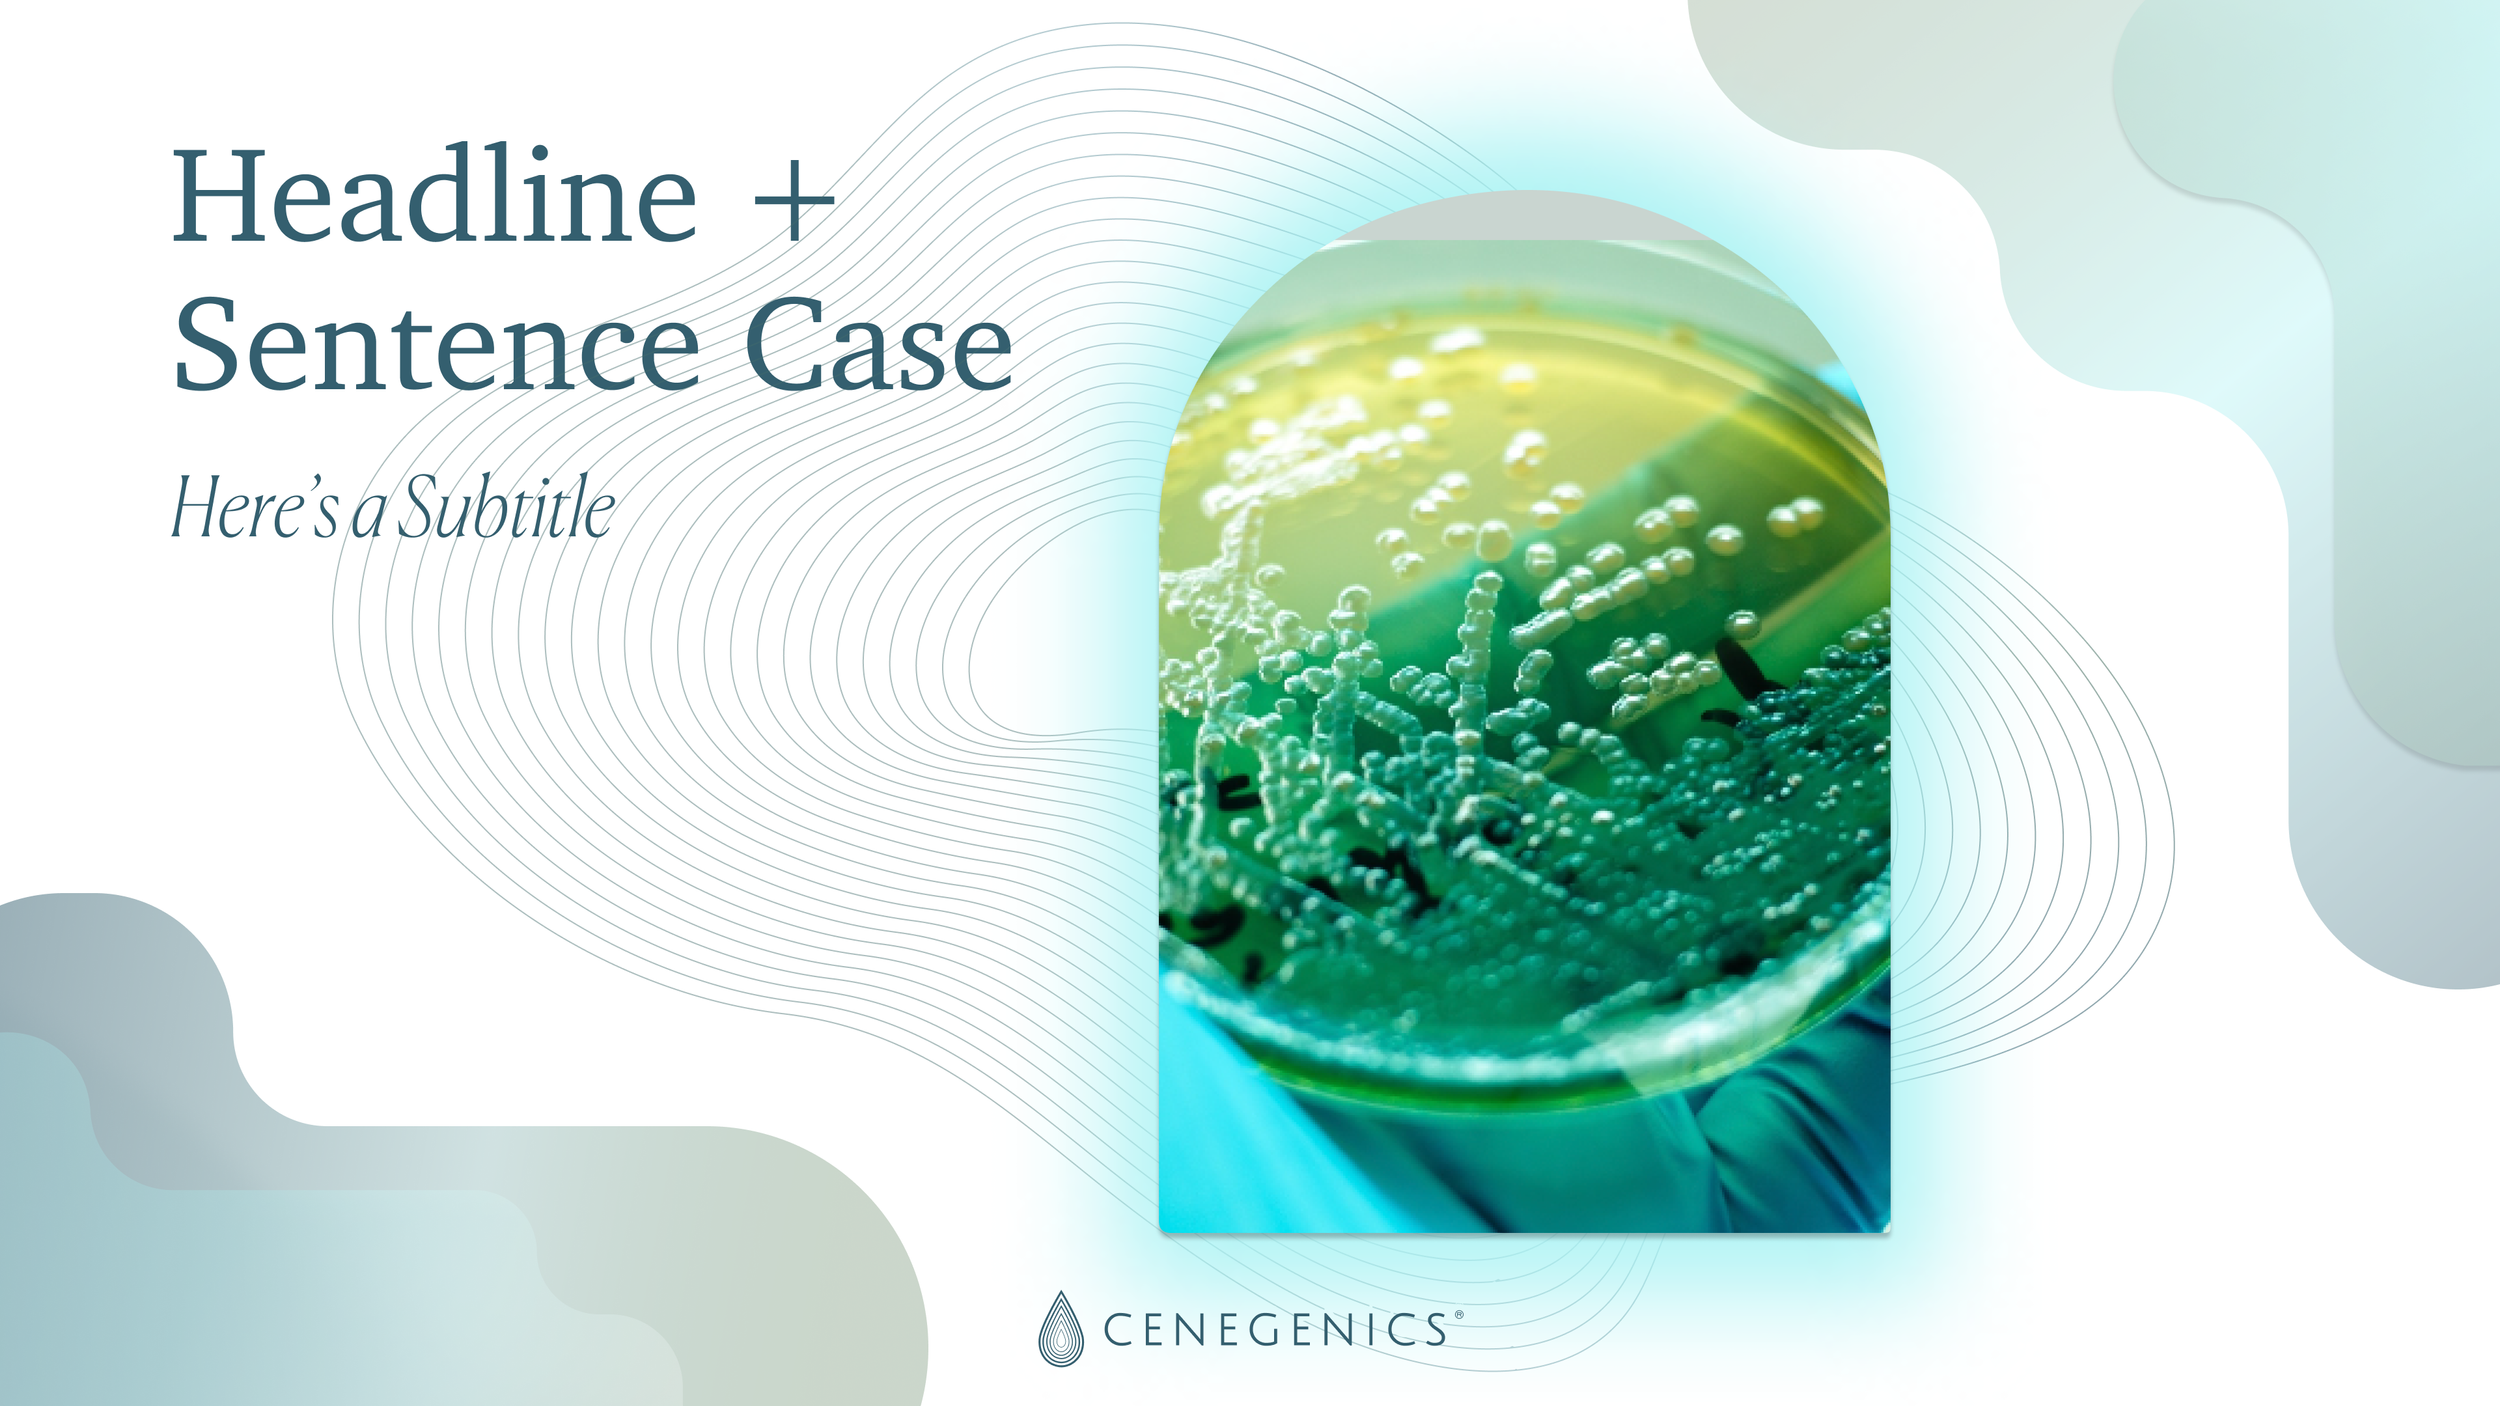
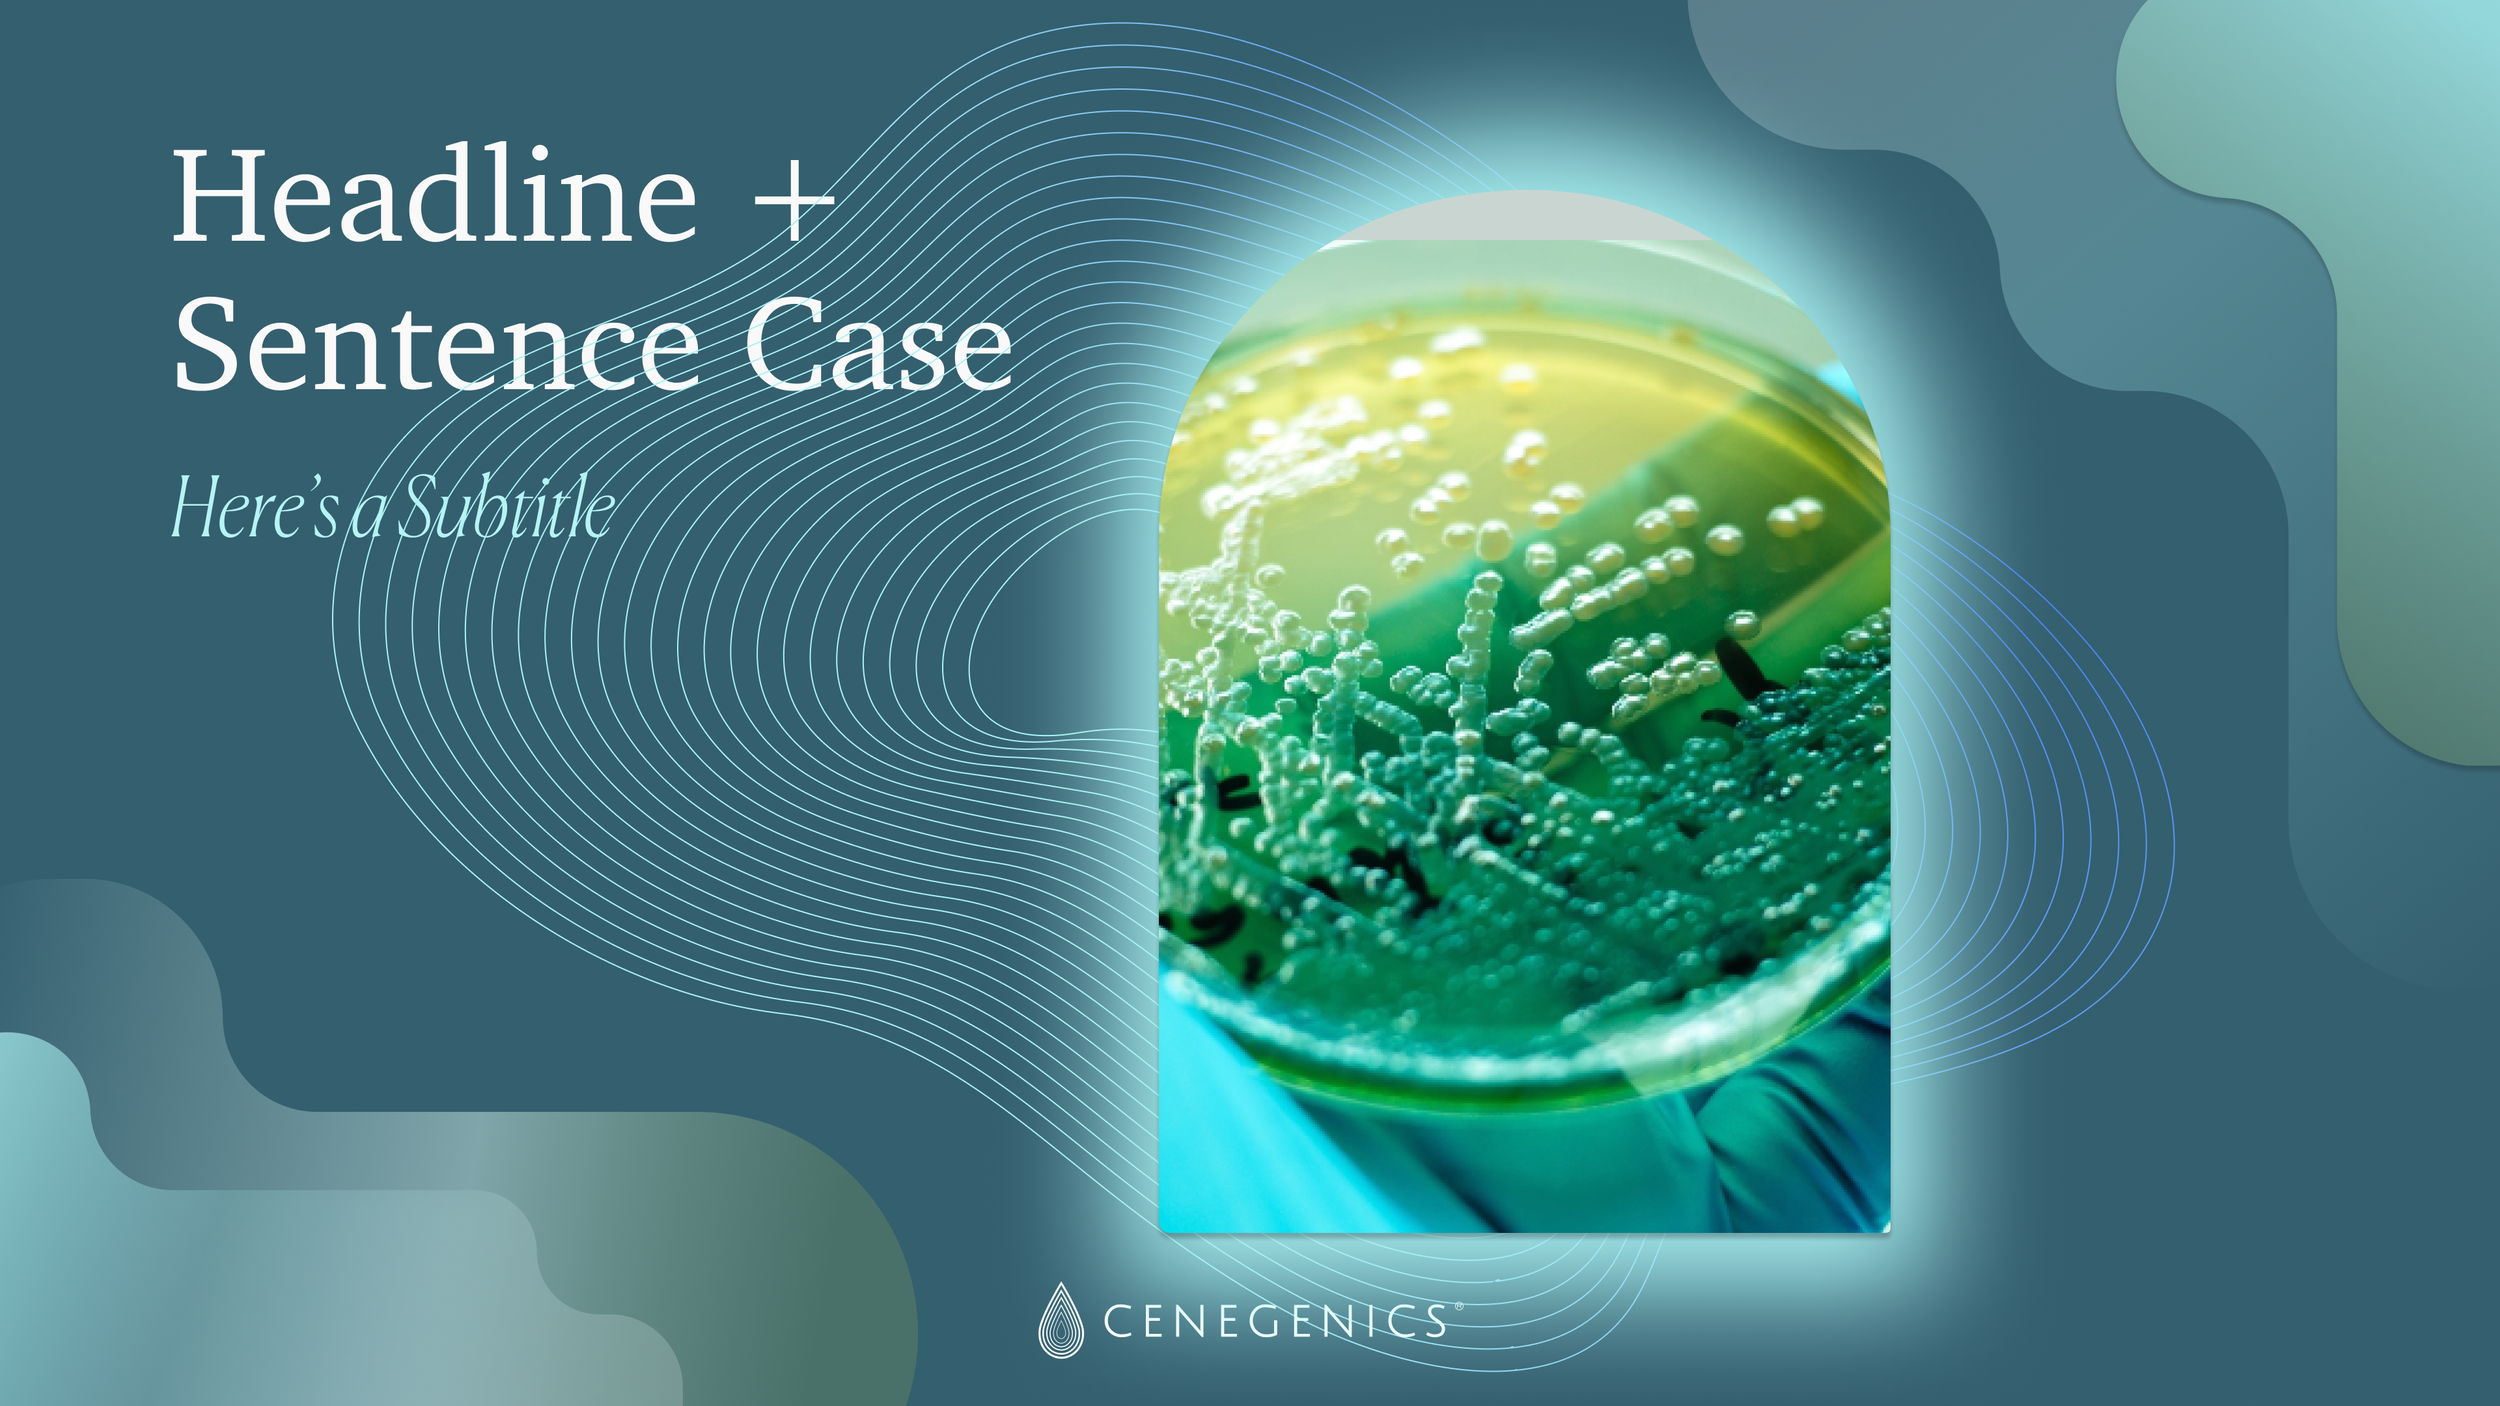

Cenegenics, 2024, Design / Brand / Creative Direction
Janie Marshall led the complete rebrand of Cenegenics, transforming the nation’s leading age management practice into a sleek, aspirational, and modern luxury wellness brand. The new site embodies a refined minimalism—crisp sans-serif typography, a cool and confident palette of deep navy, white, and platinum, and photography that feels both clinical and cinematic. Janie’s direction balances medical credibility with lifestyle allure, positioning Cenegenics as not just a healthcare provider, but a concierge-level partner in longevity. Every touchpoint—from the intuitive user flow to the editorial-style visuals—reflects her ability to distill complex services into an elegant, trust-building digital experience.